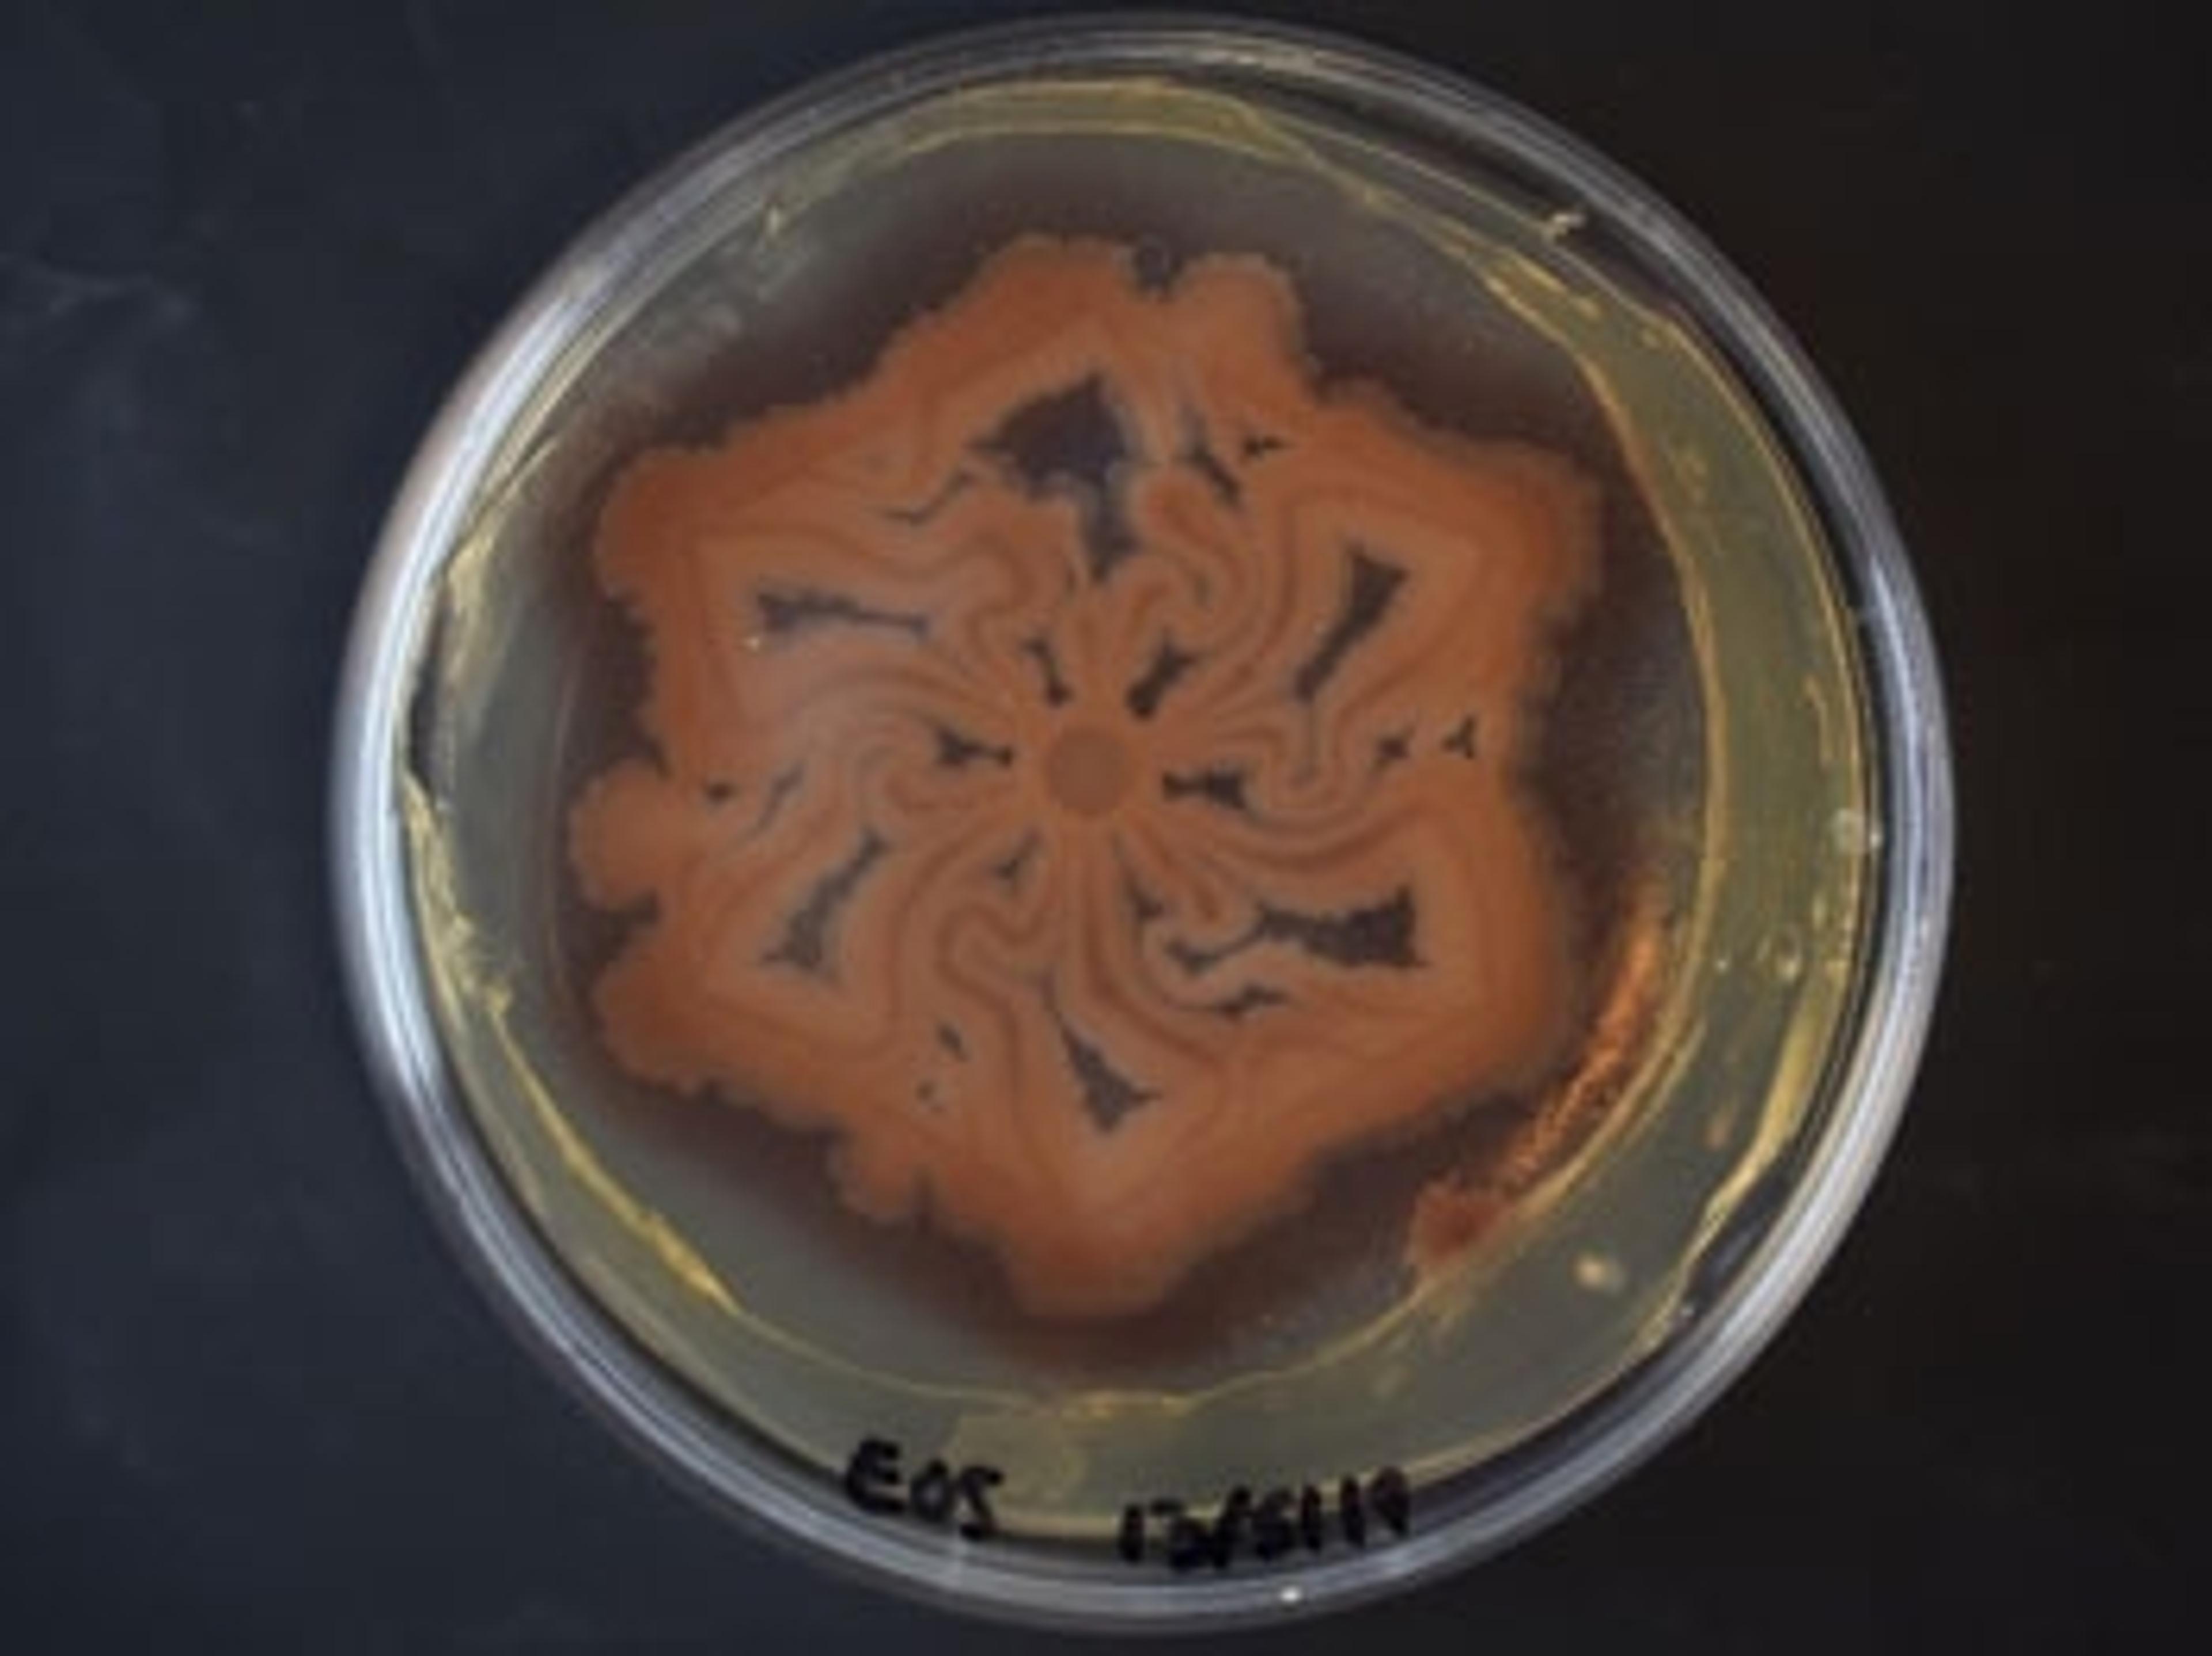

Discover the genetic dependencies of antibiotic function
Join us on Friday, June 19, to find out how massively parallel microbial strain engineering may lead to the development of novel therapeutics to combat the most difficult antibiotic-resistant pathogens